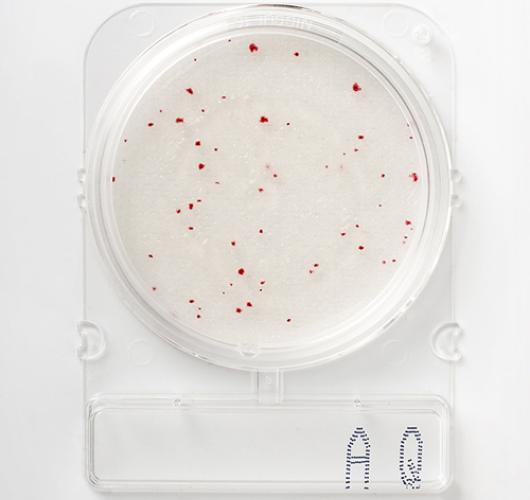

Подложки гетеротрофных бактерий в питьевой воде - Compact Dry AQ
Подложки гетеротрофных бактерий в питьевой воде - Compact Dry AQ
Готовая к использованию сухая хромогенная готовая среда для выявления гетеротрофных бактерий.
Побложка обеспечивает питательную среду для бактерий, специально адаптированных к условиям жизни с высоким содержанием питательных веществ.
Она способствует росту гетеротрофных бактерий в пробах питьевой воды. Стандартные методы определения общей микробной численности гетеротропных бактерий в воде; Обычно для этого требуется среда, богатая питательными веществами, и инкубация при температуре 36 ± 1 °C. В таких условиях можно обнаружить только часть микроорганизмов, действительно присутствующих в образце. Компактная подложка имеет более длительное время инкубации и более низкий температурный диапазон. Таким образом, можно возродить и культивировать даже бактерии, подвергшиеся стрессу или устойчивые к хлору. С помощью нее можно наблюдать рост таких микроорганизмов, как бактерии, дрожжи и плесень.
Цвет колоний: красный.
Температура и время инкубации: 72 часа при 22 ± 2°C (ISO 6222) или 48 часов при 36 ± 2°C.
Срок годности: 12–18 месяцев / 5–30°C.